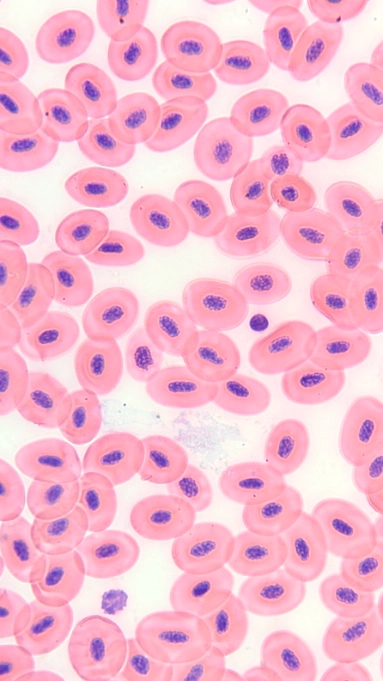
Frog Blood

A beautiful Diatom
A stunning short video of this large diatom gently sliding across the slide.
Watch on YouTubeA collection of visuals from the micro to the macro.
A stunning short video of this large diatom gently sliding across the slide.
Watch on YouTubeThis ciliate was full of crystals and I was able to capture it in a short video.
Watch on YouTubeVideo of a beautiful Paramecium Bursaria at 400X and 600X magnification.
Watch on YouTubeSee cytoplasmic streaming (or cyclosis) in moss!
Watch on YouTube
Micrograph of a freshwater algae sample, observed under brightfield microscopy at 400X magnification.
AmScope M620
Micrograph of a freshwater colonial green alga sample, observed under brightfield microscopy at 400X magnification.
AmScope M620
Micrograph of a freshwater algae sample, observed under brightfield microscopy at 400X magnification.
AmScope M620
Micrograph of a freshwater algae sample, observed under brightfield microscopy at 100X magnification.
AmScope M620
Micrograph of a freshwater Fragilaria Diatom sample, observed under brightfield microscopy at 400X magnification.
AmScope M620
Micrograph of a Paramecium Bursaria, observed under brightfield microscopy at 600X magnification.
AmScope M620
A micrograph showing a longitudinal cut of a corn seed, revealing its internal structures like the embryo and endosperm.
Darwin M2
This micrograph displays a cross-section of a pumpkin stalk, highlighting the vascular bundles (xylem and phloem).
Darwin M2
A micrograph of a thin cross-section from a lily ovary, showing the arrangement of ovules within the locules.
Darwin M2
This micrograph displays a cross-section of a cotton stem, highlighting the distinct vascular ring composed of xylem and phloem that separates the cortex from the central pith.
Darwin M2
This micrograph displays a cross-section of a Helianthus (sunflower) stem, highlighting the characteristic ring of discrete vascular bundles containing xylem and phloem
Darwin M2
This micrograph displays a cross-section of a Loosestrife stem, highlighting the large, star-shaped central vascular cylinder and the prominent trichomes on the epidermis.
Darwin M2
The classic cellular structure of an onion's epidermal cells, with distinct cell walls and nuclei, is clearly visible.
Darwin M2
A micrograph of pine pollen grains, famous for their 'Mickey Mouse' shape due to two large air sacs (sacci).
Darwin M2
A cross-section of a pine leaf, detailing its unique needle-like structure with a central vascular bundle and resin ducts.
Darwin M2
A cross-section of a pine leaf, detailing its unique needle-like structure with a central vascular bundle and resin ducts.
AmScope M620
This micrograph shows a cross-section of a pine stem. Clearly visible are the concentric annual growth rings, the central pith, and numerous resin canals scattered throughout the vascular tissue.
AmScope M620
A longitudinal section of a male (staminate) pine cone. This view reveals the numerous microsporophylls attached to a central axis, each bearing microsporangia (pollen sacs) filled with developing pollen grains.
AmScope M620
This micrograph displays a longitudinal section of a young female (ovulate) pine cone. It highlights the arrangement of ovuliferous scales along a central axis, with each scale bearing two ovules on its upper surface, which will develop into seeds upon fertilization.
AmScope M620
A micrograph of an ant, showcasing the fine details of its exoskeleton, antennae, and segmented body.
Darwin M2
The delicate, veined structure of a bee's wing is visible in this micrograph, including the tiny hairs covering its surface.
Darwin M2
A detailed look at a bee's foreleg, highlighting the antenna cleaner, a specialized notch and bristle structure.
Darwin M2
This micrograph displays a whole mount of a housefly leg, highlighting its distinct segmentation into a femur, tibia, and tarsus, as well as the numerous sensory bristles and terminal claws
Darwin M2
This micrograph displays a whole mount of a housefly (Musca) leg, highlighting the joint between the bristled tibia and the segmented tarsus, which terminates in claws and adhesive pads.
Darwin M2
A close-up view of the overlapping, cycloid scales of a goldfish, showing the growth rings (circuli).
Darwin M2
A close-up view of Frog Blood. Captured with a AmScope M620 microscope.
AmScope M620
A full moon capture using the Dwarf 3
Dwarf 3
The beautiful Heart Nebula
Dwarf 3
The Soul Nebula captured using the Dwarf 3
Dwarf 3
The Pelican Nebula captured using the Dwarf 3
Dwarf 3
The North American Nebula captured using the Dwarf 3
Dwarf 3
The North American Nebula in Hubble HSO Colours captured using the Dwarf 3
Dwarf 3
The Pinwheel Galaxy captured using the Dwarf 3
Dwarf 3
A Waning Gibbous Moon capture during the day using the Dwarf 3
Dwarf 3